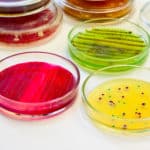
Boost or Bust? Scientists find Potential Weapon against Antibiotic Resistance

Home Search
microbiology - search results
If you're not happy with the results, please do another search
R&D Job Openings @ NIVEDI | SRF Positions in ICMR Project
R&D Job Openings @ NIVEDI | SRF Positions in ICMR Project
This job expires in :
A Walk in interview for one· position each of Research...
Biotecnika Times – Newsletter 19.12.2017
Govt Research Fellow Vacancy @ IPFT, Ministry of Chemicals & Fertilizers
Institute of Pesticide Formulation Technology (IPFT) is an Autonomous Institution, established / set up...
Microscope-Based AI Could Alleviate Shortage of Clinical Microbiologists
Microscope-Based AI Could Alleviate Shortage of Clinical Microbiologists
"This marks the first demonstration of machine learning in the diagnostic area," said senior author James Kirby,...
Novozymes Hiring For the Post of QC Microbiologist
Novozymes Hiring For the Post of QC Microbiologist
Novozymes is the world leader in biological solutions. Together with customers, partners and the global community, we...
Notification for Tamil Nadu State Eligibility Test – TNSET 2018 for Assistant Professor
Notification for Tamil Nadu State Eligibility Test - TNSET2018 for Assistant Professor
This call expires in :
Important Instructions:
The candidates have to read this Notification...
Project Fellow Position for MSc Candidates @ Kalyani University
Project Fellow Position for MSc Candidates @ Kalyani University
This job expires in :
Applications are invited for the post of a Project Fellow for the...
Biotecnika Times – Newsletter 15.12.2017
ICMR International Fellowships 2018-19 | 18 Fellowships Available
The Indian Council of Medical Research (ICMR) invites applications from Indian Biomedical Scientists for the ICMR International Fellowships for the...
CIMAP-JNU Ph.D. Programme (2018-2019)
CIMAP-JNU Ph.D. Programme (2018-2019) | Walk-In-Interview
This job expires in :
CSIR-Central Institute of Medicinal and Aromatic Plants (CSIR-CIMAP) is a constituent laboratory of Council of Scientific...
Biotecnika Times – Newsletter 13.12.2017
194+ BioTecNika students shine in CSIR NET June 2017 Exam, Watch their Success Stories
Its indeed a happy moment, Some of you have made us...
Biotech’s Next Big (Blue) Platform: Startup Secures $13M for Tech Using Algae to Make...
Startup Secures $13M for Tech Using Algae to Make Biologics
Used first as a high-protein, high-vitamin, antioxidant nutritional supplement, Spirulina extract sales soared after its...
40+ JRF Posts For Life Sciences Candidates @ CSIR-IICB
40+ JRF Posts - Life Sciences Candidates @ CSIR-IICB
This job expires in :
The Institute was established in 1935 as the first non official centre...
Dr. Rita Colwell Wins Top International Biology Prize
Dr. Rita Colwell Wins Top International Biology Prize
Rita Colwell, distinguished professor in the University of Maryland's cell biology and molecular genetics department, has been...
Boost or Bust? Scientists find Potential Weapon against Antibiotic Resistance
Scientists find Potential Weapon against Antibiotic Resistance
Resistance to antibiotics by bacteria and other microbes is an ongoing public health crisis, contributing to about two...
Biotecnika Times – Newsletter 04.12.2017
BIRAC Innovation Fellowship Under CIC-B @ Panjab University
Advertisement for one position of BIRAC Innovation fellow (purely temporary basis)
under Cluster Innovation Centre.............. Read More
PhD Admissions 2018...
PhD Admissions 2018 @ International Max Planck Research School
PhD Admissions 2018 @ International Max Planck Research School
The application closes in :
Since 2003 the International Max Planck Research School for Environmental, Cellular and Molecular...